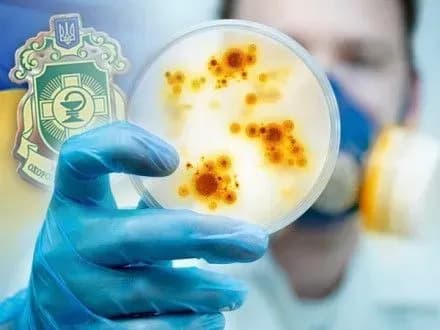
В.Медведчук: смерть від ботулізму - побічний ефект євроінтеграції

В.Медведчук: смерть від ботулізму - побічний ефект євроінтеграції
Київ • УНН
КИЇВ. 9 червня. УНН. Сьогодні у всьому цивілізованому світі з ботулізмом успішно борються за допомогою протиботулінічної сироватки. Але в Україні цієї антитоксичної сироватки в лікарнях просто немає. Таку думку висловив лідер Громадянського руху "Український вибір - Право народу " Віктор Медведчук, передає УНН.
"Медики б'ють на сполох - в Україні масовий спалах ботулізму. Випадки захворювання зафіксовані в Київській, Сумській, Запорізькій, Полтавській, Вінницькій та Херсонській областях. Хворі перебувають у важкому стані, одного з них лікарям врятувати не вдалося", - заявив В.Медведчук.
"Ботулізм - вкрай небезпечне захворювання, яке може привести до летального результату, якщо своєчасно не надати медичну допомогу. Однак сьогодні в усьому цивілізованому світі з ботулізмом успішно борються за допомогою протиботулінічної сироватки. Але в Україні цієї антитоксичної сироватки в лікарнях просто немає. І якщо рідні і близькі не зможуть на свій страх і ризик дістати її (як правило, ввезену нелегально, іноді з порушенням умов зберігання і транспортування), хворий приречений. Тому, як заявив керівник столичної Госпродпотребслужби Олег Рубан, "на сьогоднішній день ми можемо сказати, що ботулізм в Україні - це смертельно небезпечне захворювання". За словами чиновника, в країні "відсутня повністю як діагностика, так і специфічна сироватка проти ботулізму...", - підкреслив політик.
Виникає закономірне питання: невже Україна не має коштів на закупівлю медикаментів, які рятують життя смертельно хворим пацієнтам? Виявляється, причина не у відсутності фінансування, а в ... політичних іграх. Справа в тому, що в 2014 році Україна в рамках антиросійських санкцій відмовилася від медикаментів, вироблених в РФ, в тому числі від вакцин і сироваток. "... Великої біди для здоров'я українців від санкцій не буде", - запевняв що був тоді міністром охорони здоров'я Олег Мусій.
На думку політика, псевдопатріотичне оптимізм чиновника обернувся злочинної безвідповідальністю його послідовників: відмовившись від російських вакцин і сироваток, Україна вже третій рік не може зареєструвати препарати інших виробників. Два роки тому Олександр Квіташвілі, який очолював у той час Міністерство охорони здоров'я, клятвено обіцяв, що польська сироватка від ботулізму ("високої якості сироватка, що не російського виробництва") надійде в Україну і почне розподілятися по країні "на початку наступного тижня". Але ні при Квіташвілі, ні при в.о. міністра охорони здоров'я Уляни Супрун сироватка, від якої залежить життя і здоров'я українців, в лікарнях так і не з'явилася. Більш того, пані Супрун уникає питань на цю тему.
Після того як на прес-конференції у неї поцікавилися, коли в Україні з'явиться протиботулінічна сироватка і скільки людей ще має померти, щоб МОЗ нарешті провів необхідні закупівлі, глава відомства, "реформатор" американського розливу, просто ганебно втекла від журналістів. Втім, питання, що стосуються здоров'я і життя українців, здається, найменше цікавлять У.Супрун. Зате її вкрай турбує, що в Україні все ще зареєстровано багато ліків з РФ, а тому в Міністерстві охорони здоров'я готують "зміни в указ президента, щоб ліки та медичні вироби, вироблені в Росії, потрапили під санкції. Щоб ті ліки, які все ще можна закуповувати, - заборонити".
"Пані Супрун навіть не замислюється про справжню ціну своїх "реформ" і про українців, яким доводиться розплачуватися своїм здоров'ям, а часом і життям за злочинні дії або бездіяльність чиновників МОЗ. По суті, те, що сьогодні відбувається в профільному міністерстві, дуже коротко і ємко вже охарактеризував хірург зі світовим ім'ям Борис Тодуров, який прямо заявив в.о. міністра Супрун: "... Ваша недбалість забрала більше життів українців, ніж війна за останні роки", - резюмував В.Медчедвук.